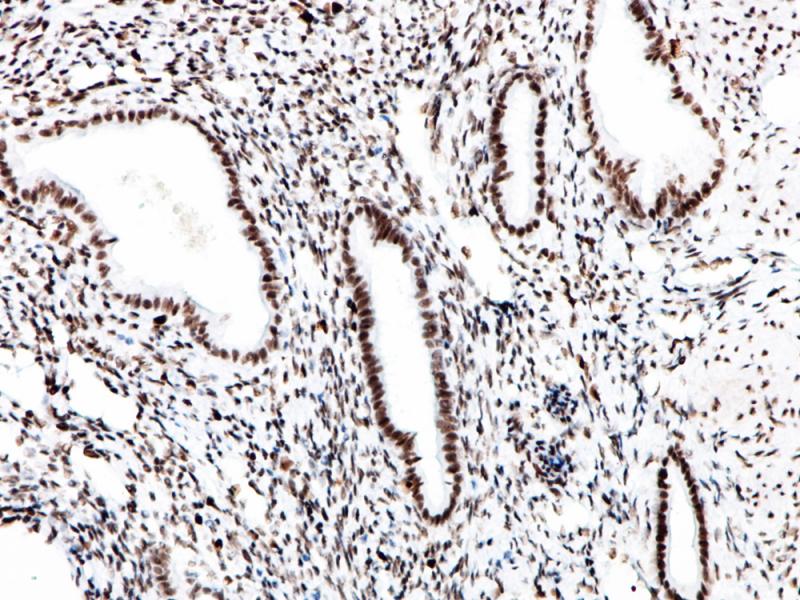
子宫 MSH6 (BP6007) 染色

产品中心

结肠 MSH6 (BP6007) 染色
子宫 MSH6 (BP6007) 染色
MSH6 重组兔单克隆抗体
MSH6是一种错配修复蛋白,在大部分微卫星不稳定(MSI-H)患者中是缺陷的;此外,MSH6在某些恶性肿瘤中也是缺陷的,如遗传性非息肉病性结、直肠癌(HNPCC)和子宫内膜癌。所有增殖细胞中均表达MSH6,其参与了DNA复制过程中的碱基错配修复。MSH6通常与MLH1、MSH2和PMS2组合检测,有助于识别发生微卫星不稳定(MSI)可能的相关基因。
Specifications
- 目录号
- BX50003
- 克隆号
- BP6007
- 阳性对照
- 结肠
- 亚细胞定位
- 细胞核
- 组织类型
- FFPE
- 修复方式
- HIER
- 稀释比
- 1:100-1:200
- 规格
- 100μl/vial, 1ml/vial
- 用途
- RUO
Reference
1.Blackwell LJ., et al. J Biol Chem. 1998 Nov27;273(48):32055-62.
2.Iaccarino I., et al. EMBO J. 1998 May 1;17(9):2677-86.


